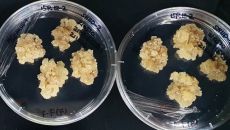

2026
일
월
화
수
목
금
토
-

메드팩토, 면역항암 신약 ‘MP010’ 국가신약개발 과제 선정
메드팩토는 신규 면역항암치료제 ‘MP010’이 국가신약개발사업단(KDDF) 주관 2025년도 제2차 국가신약개발사업 신규 과제- 2025-11-19 17:49
- 매일경제
-
"장미 향 성분 그대로 살린다"···K뷰티 경쟁력도 뒷받침
그린바이오 기술은 화장품이나 의약품 등 분야에서도 중요성이 부각되고 있다. 최근에는 종자·곤충 등을 활용하는 그린바이오 기술도- 2025-11-19 17:49
- 서울경제
-

[포토] 34년 활약한 장보고함 '마지막 항해'
[ⓒ 매일경제 & mk.co.kr, 무단 전재, 재배포 및 AI학습 이용 금지]- 2025-11-19 17:49
- 매일경제
-

강경화 "대북정책 美지지 확보할것"
강경화 주미대사(사진)가 "미국 측과 긴밀히 소통하는 가운데 대북정책에 대한 지지를 계속 확보해 나가겠다"고 18일(현지시간)- 2025-11-19 17:49
- 매일경제
-
철강업계 지원 'K스틸법' 국회 소위 문턱넘어
미국 관세와 중국 저가 공세 등 이중고에 빠진 국내 철강산업을 지원하기 위한 'K스틸법'이 국회 산업통상자원중소벤처기업위원회 법안소위원회를 통과하며 첫- 2025-11-19 17:49
- 매일경제
-

미국해군이 미성년자 성추행…오키나와 발칵, 주지사 “용납 못해”
일본에 주둔하는 미국 해군 군인이 오키나와에서 일본인 청소년을 성추행한 사실이 알려지면서 지역사회의 공분을 사고 있다. 19일- 2025-11-19 17:49
- 매일경제
-

정청래 "대구부터 살리겠다 … 지역발전 동반자 될것"
정청래 더불어민주당 대표가 19일 취임 후 처음으로 대구를 방문해 "대구가 민주당으로서는 어려운 지역임에는 분명하지만, 민주당- 2025-11-19 17:49
- 매일경제
-

김용범 "대출규제로 시간벌어 … 주택공급 몇 달내 성과내겠다"
김용범 대통령실 정책실장(사진)이 10·15 부동산 대책은 응급 조치였다며 "필사적으로 관계장관회의를 구성해 주택 공급 방안을- 2025-11-19 17:49
- 매일경제
-

최태원 만난 장동혁 "기업 족쇄 풀겠다"
장동혁 대표를 포함한 국민의힘 지도부가 19일 최태원 대한상공회의소 회장을 만나 기업의 족쇄를 푸는 데 최선을 다하겠다고 밝혔- 2025-11-19 17:49
- 매일경제
-

하이로닉, 2025 대한리프팅학회서 ‘시너젯’ 강연 진행
글로벌 미용의료기기 기업 ㈜하이로닉은 지난 16일 서울 코엑스 컨벤션센터에서 열린 ‘2025 대한리프팅학회 제7회 학술대회 및- 2025-11-19 17:49
- 스포츠월드
-

'우주 헤리티지' 쌓고 기술력 강화···누리호에 큐브위성 싣는 벤처기업
누리호 4차 발사가 일주일 앞으로 다가온 가운데 벤처 기업들의 관심도 나로우주센터로 향하고 있다. 이번 누리호 4차 발사에는- 2025-11-19 17:49
- 서울경제
-

"미친 X" "자빠졌네"…국힘, 與부승찬·장경태·최혁진 징계안 제출
아시아투데이 이체리 기자 = 국민의힘은 19일 더불어민주당 부승찬·장경태 의원과 최혁진 무소속 의원이 자당 의원들에게 막말을- 2025-11-19 17:49
- 아시아투데이
-

조동주 이랜드월드 대표 "물류센터 화재에도 생산 빠르게 안정화"
조동주 이랜드월드 대표가 충남 천안시 패션물류센터 화재 후속 조치와 관련해 "물류 인프라와 거점 물류 시스템을 통해 온라인 배- 2025-11-19 17:49
- 아주경제
-

[비즈톡톡] ‘장수 게임’으로 승부… 엔씨 김택진·크래프톤 장병규도 힘 싣는 IP 브랜드화 전략
국내 주요 게임사들이 인기 게임 지식재산권(IP)의 브랜드화에 박차를 가하고 있습니다. 탄탄한 팬층을 보유한 히트작의 세계관을- 2025-11-19 17:49
- 조선비즈
-

‘K스틸법’ 산자위 소위 통과… 이르면 11월 중 본회의 통과
철강업계의 사업 재편 및 탈탄소화 기술 개발을 지원하는 ‘철강산업 경쟁력 강화 및 녹색철강기술 전환을 위한 특별법(K-스틸법)- 2025-11-19 17:49
- 세계일보

